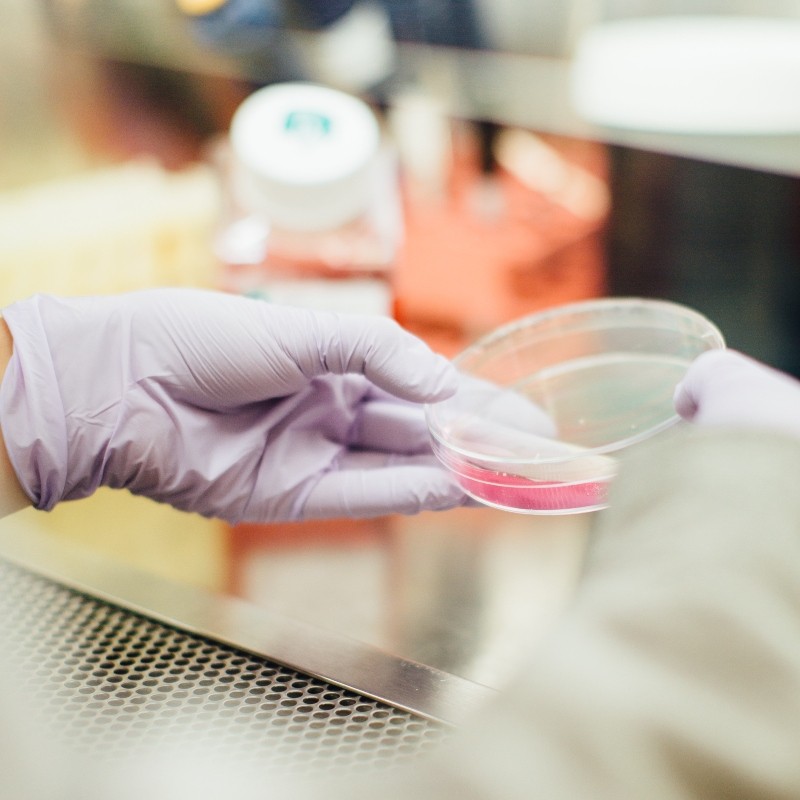

ΥΓΕΙΑ
-
 ΥΓΕΙΑΔιαβήτης: Μία 2 σε 1 ένεση βοηθά να ελεγχθεί το σάκχαρο στο αίμα
ΥΓΕΙΑΔιαβήτης: Μία 2 σε 1 ένεση βοηθά να ελεγχθεί το σάκχαρο στο αίμα -
 ΥΓΕΙΑCovid-19: Bιοφαρμακευτική εταιρεία στην California ισχυρίζεται ότι έκανε μια σημαντική ανακάλυψη αντισωμάτων
ΥΓΕΙΑCovid-19: Bιοφαρμακευτική εταιρεία στην California ισχυρίζεται ότι έκανε μια σημαντική ανακάλυψη αντισωμάτων -
 ΥΓΕΙΑΠΟΥ: Προειδοποιεί ότι ο κορονοϊός μπορεί να μείνει ενεργός για άλλα πέντε χρόνια
ΥΓΕΙΑΠΟΥ: Προειδοποιεί ότι ο κορονοϊός μπορεί να μείνει ενεργός για άλλα πέντε χρόνια -
 ΥΓΕΙΑΗνωμένο Βασίλειο: Παραγγέλνει εκατομμύρια τεστ αντισωμάτων ακριβείας για δημόσια χρήση
ΥΓΕΙΑΗνωμένο Βασίλειο: Παραγγέλνει εκατομμύρια τεστ αντισωμάτων ακριβείας για δημόσια χρήση -
 ΥΓΕΙΑΒιταμίνη D: Μπορεί να μας προστατεύσει από αναπνευστικές λοιμώξεις;
ΥΓΕΙΑΒιταμίνη D: Μπορεί να μας προστατεύσει από αναπνευστικές λοιμώξεις; -
 ΥΓΕΙΑΤι σημαίνει ο όρος «ασυμπτωματική» πάθηση
ΥΓΕΙΑΤι σημαίνει ο όρος «ασυμπτωματική» πάθηση -
 ΥΓΕΙΑΓυμνάζουμε όλο το σώμα με τη βοήθεια ενός kettlebell
ΥΓΕΙΑΓυμνάζουμε όλο το σώμα με τη βοήθεια ενός kettlebell -
 ΥΓΕΙΑΕμμηνόπαυση και καρδιαγγειακή υγεία: Τι πρέπει να προσέξετε
ΥΓΕΙΑΕμμηνόπαυση και καρδιαγγειακή υγεία: Τι πρέπει να προσέξετε -
 ΥΓΕΙΑΕπιστημονικό επίτευγμα για το Ισραήλ: Ένα βήμα πιο κοντά στη θεραπεία του covid-19
ΥΓΕΙΑΕπιστημονικό επίτευγμα για το Ισραήλ: Ένα βήμα πιο κοντά στη θεραπεία του covid-19 -
 ΥΓΕΙΑΚαρκίνος σε πρώιμο στάδιο ανιχνεύεται με εξετάσεις αίματος
ΥΓΕΙΑΚαρκίνος σε πρώιμο στάδιο ανιχνεύεται με εξετάσεις αίματος